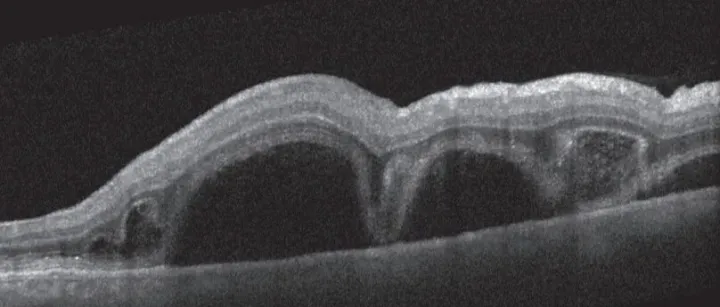
Vogt-小柳-<em>原田</em>综合征（Vogt-Koyanagi-Harada，VKH）

搜索

环球易购
专注于服装电子等多个垂直品类的跨境出口零售服务。
“原田易购的商业模式”相关文章查看更多
>
共10000篇文章
综合 | 最新

跨境资讯
刘易讲师-商业模式设计专家 

老A讲跨境
1个月前
跨境资讯
闲置的苏宁易购礼品卡怎么处理 

Alisa的外贸笔记
2个月前
跨境资讯
苏宁易购博西家电剧透新打法 

苏宁易购蓝话筒
3周前
跨境资讯
闲置的苏宁易购礼品卡新处理方式介绍 

Lisa聊外贸
1个月前- <
- 1
- 2
- 3
- ...
- 1000
- >
“原田易购的商业模式”相关服务
查看更多“原田易购的商业模式”相关企业查看更多企业 >
共10000个企业
企业名称 类型 地区 规模 融资

环球易购 专注于服装电子等多个垂直品类的跨境出口零售服务。
服务商
深圳市
1001-5000人
-

华联易购 华联易购是深圳市华联易购科技有限公司旗下的品牌,该企业专注于国际跨境贸易,并深度融合互联网营销与服务,是一家电子商务公司。
服务商
深圳市
51-200人
-

奢易购 北京奢易购网络科技有限公司(sheyigou
服务商
南昌市
11-50人
-

苏宁易购 苏宁易购,是苏宁电器旗下新一代B2C网上购物平台(www
服务商
南京市
1001-5000人
-

环球易购电子商务 深圳市环球易购是一家跨境B2C电子商务网站,专注于服装电子等多个垂直品类的跨境出口零售服务,旗下有服装类平台sammydress。com、3C电子产品类平台everbuying。com等。
服务商
深圳市
1001-5000人
-
- <
- 1
- 2
- 3
- ...
- 2000
- >
“原田易购的商业模式”相关作者
共72个作者


出口易 值得信赖的跨境电商全程物流解决方案服务商,专注全球海外仓配、空运专线、国际头程、小包快递等跨境物流服务。
总阅读 88.1k
粉丝 2
内容 65


Oceanpayment Oceanpayment作为拥有全球数字支付技术和业务资质的全牌照FinTech公司,致力于为互联网B2C(B)商业模式提供全球数字支付技术解决方案和服务。
总阅读 0
粉丝 0
内容 0


跨境林哥 测评环境系统研发及测评自养号技巧教学,一天成号环境系统,深度解决防关联、防封号及易砍单
总阅读 96.8k
粉丝 1
内容 11


跨境电商洪哥 擅长测评环境系统研发及测评养号技巧教学,深度解决防关联、防feng号及易kan单问题,欢迎技术交流,
总阅读 499.6k
粉丝 2
内容 148


Ellen的出海笔记 分享网站优化(SEO)与海外广告投放(SEM)实用技巧,只为助力中国品牌出海。
总阅读 7.9k
粉丝 1
内容 3
- <
- 1
- 2
- 3
- ...
- 15
- >
“原田易购的商业模式”相关报告 查看更多报告 >
共2531个报告

跨境报告
2025-02-13 00:00
易启捷思Ekimetrics:2025亚太消费市场营销攻略白皮书出海品牌的营销致胜之道
易启捷思Ekimetrics:2025亚太消费市场营销攻略白皮书出海品牌的营销致胜之道
作者: Ethan教跨境电商
- <
- 1
- 2
- 3
- ...
- 282
- >
活动
服务
百科
问答
文章
社群
跨境企业